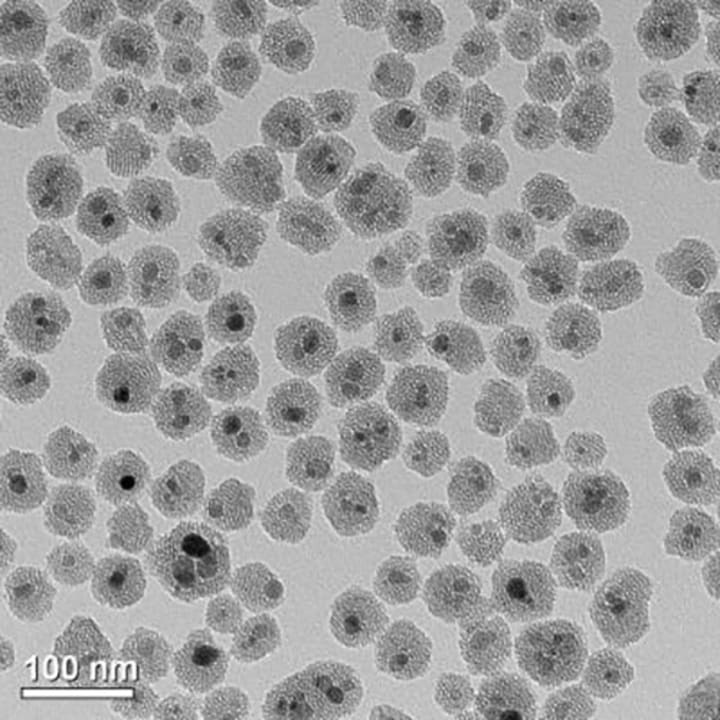

Catching 40 Billion Winks
Getting the Han Solo-Carbonite Treatment Because Space is Boring

Humanity’s first trip to a distant star is likely to be boring. I’m not talking I’m-so-bored-I-can’t-find-anything-to-watch-on-237-cable-channels-or-Netflix kind of bored. I mean stuck-in-a-doctor’s-office-with-muzak-and-no-magazines-with-no-escape-for-20-years kind of bored. Think of it this way, it would be like a cruise ship without the water, ports, destinations, wave pools, an open bar or anything to even really look at. Oh, and the food would probably suck pretty bad, too.
It’s too bad space travel isn’t like a VCR tape. Okay, fine. Too bad space travel isn’t like a DVR. (You happy people-who-live-in-the-present-and-don’t-like-retro-things?) Someday that might just be possible, thanks to the wonders of…
SCIENCE...ience...ience...ience…
Skipping past all the boring parts of space travel? Yes, please and thank you! Enter cryosleep, the ability to lay down on a super-high-tech bed, let the lid close down on you and never wake up because an alien bursts through your chest while you’re asleep. Ok, skip that last part. You get to sleep then wake up when your ship gets close to your new home planet, Earth 2, or New Earth, or something else completely unoriginal.
Back to the science.
Cryosleep is one of the mainstays of science fiction, from Star Trek to the Aliens to 2001: A Space Odyssey and Red Dwarf. It’s based on the real-world tech category called cryonics, or cryogenics, which is the ability to freeze a living thing to put it into a form of suspended animation, then reawaken it sometime later with little to no change in the subject. Pretty cool, huh? (Pun intended, peeps.)
Think of it like this. At the end of The Empire Strikes Back, Han Solo is frozen in carbonite. This is supposed to be a form of suspended animation. Of course, in the Star Wars universe, carbonite freezing is for cargo, not living things. And while freezing things in carbonite is totally not a real thing, that does not stop some people from trying to figure out if that could actually be done.

"He's no good to me dead." ~ Boba Fett
Peter Hess, over at Inverse Sciencerecently did a thought experiment to examine this. Let’s just say reality would probably not have been so kind to Mr. Solo. That, and he’d never have been able to spawn a snotty brat who would later… ACK! SPOILER!
Sorry.
Anywho… Just because our favorite space rogue would have died and Boba Fett would not have gotten paid, does not mean that cryogenics is not a real thing. It totally is. In fact, a research team at the University of Minnesota recently made a breakthrough where they were able to rewarm large-scale animal heart valves and blood vessels that had been preserved at very low temperatures. Basically, they froze some chunks of people then warmed them back up without significant damage.

A research team, led by the University of Minnesota, has discovered a groundbreaking process to successfully rewarm large-scale animal heart valves and blood vessels preserved at very low temperatures using silica-coated iron oxide nanoparticles and non-invasive electromagnetic waves. Credit: University of Minnesota
According to John Bischof, the senior author of the study, "This is the first time that anyone has been able to scale up to a larger biological system and demonstrate successful, fast, and uniform warming of hundreds of degrees Celsius per minute of preserved tissue without damaging the tissue,"
IMAGE: A TRANSMISSION ELECTRON MICROSCOPY (TEM) IMAGE SHOWS THE IRON OXIDE NANOPARTICLES COATED IN A MESOPOROUS SILICA THAT ARE USED IN THE TISSUE WARMING PROCESS.CREDIT: HAYNES RESEARCH GROUP, UNIVERSITY OF MINNESOTA
While this may seem like it’s not super helpful at the moment in getting us to Proxima Centauri, it is helpful in the here and now. Apparently, the majority of hearts and lungs that are donated to science have to be destroyed because the degrade before scientists can use them. If they could freeze then later warm and use them, the march of science will progress even faster, saving lives. Maybe even the lives of our future co-colonists.
The problem with freezing human body parts (or whole humans for that matter), is ice crystals. When ice crystals form, they can destroy the biological subject at a cellular level, making even small pieces of material unusable. Let’s not even think about what that would do to a whole person. Yech. But, the UOM team’s new method introduces “silica-coated iron oxide nanoparticles” into the special sauce that protects the tissues. When rewarming, the nanoparticles react with noninvasive electromagnetic waves to warm the tissue all at once very rapidly. Like 100-200 degrees CELSIUS per minute. For those of us on the western side of the Atlantic? That’s 200-400 degrees Fahrenheit per minute.

Todd's new tattoo.Courtesy
The hope is that this can be scaled up to larger pieces of subject material, allowing doctors to store whole organs for future transplant. There are even some ideas of applying the tech to cancer by using hyper-targeted, lethal heat pulses on cancer cells. Wouldn’t that be cool?
For now, though, freezing in carbonite is still not recommended. Or even possible, since we don’t really know what carbonite is. Cryopreservation, cryonics, and cryosleep are not recommended for humans yet either. Someday, I think, we’ll get there, but not just yet. For now, sleeping for a hundred years and waking up with a massive need to pee will have to stay in the realm of science fiction.
About the Creator
C. A. Wilke
I like to put words together to tell stories of possible futures, mythical pasts and anything in between. I also write commentary about the interaction of science and science fiction. Find more of my work at SpeculativeMiscelllany.com




Comments
There are no comments for this story
Be the first to respond and start the conversation.